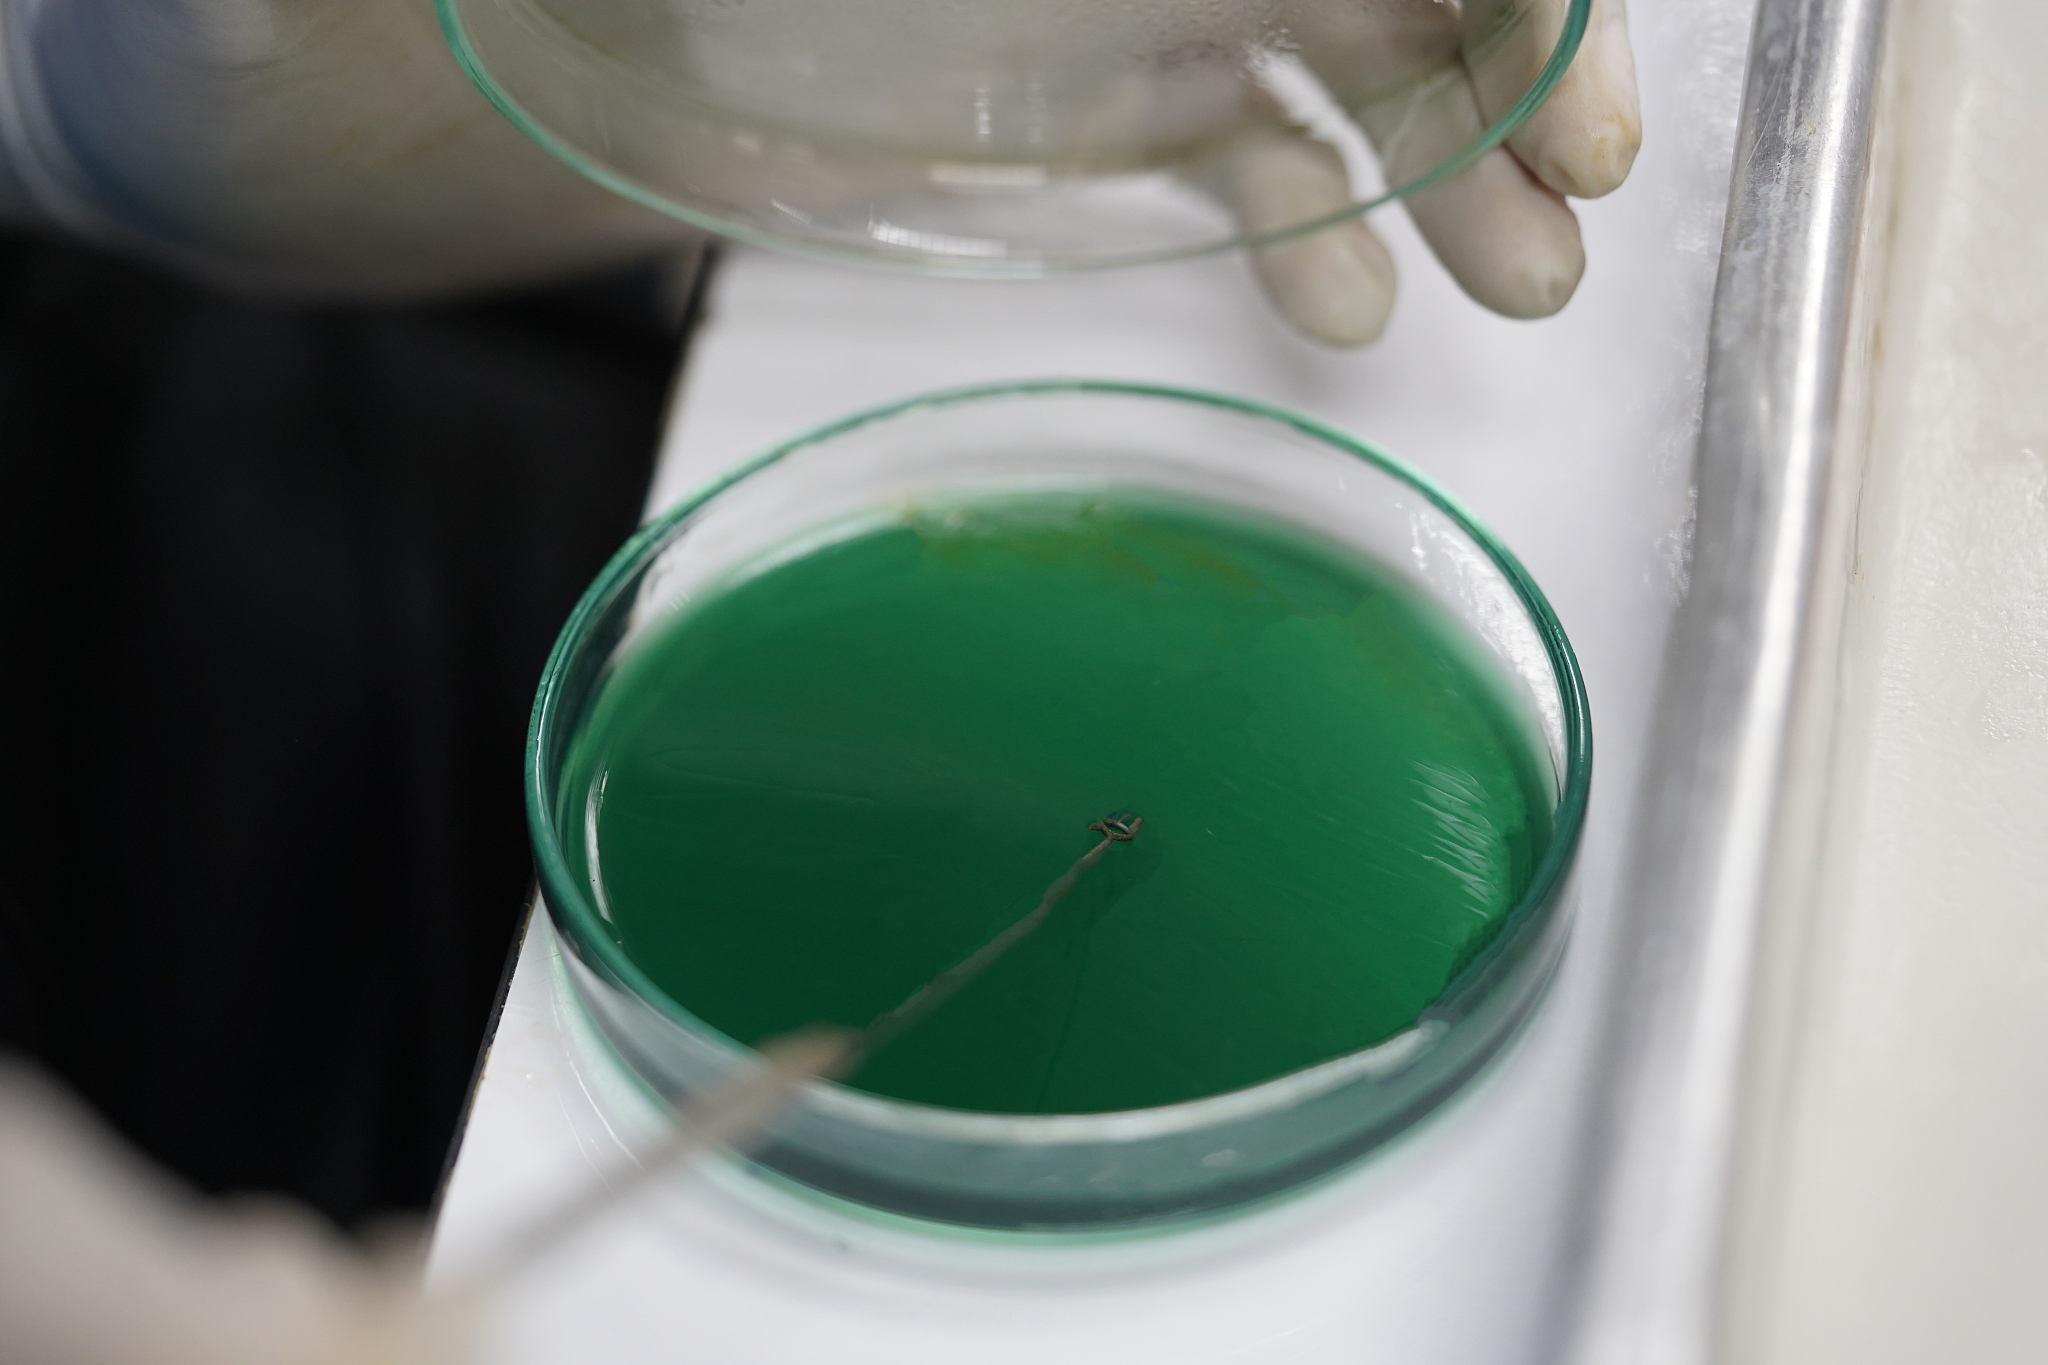
碘化铅和碱反应吗

碘化铅和碱反应吗
碘化铅可以和碱反应生成碘化物。下面是一个可能的反应方程式: PbI2 + 2NaOH → Pb(OH)2 + 2NaI 其中,PbI2 表示碘化铅,NaOH 表示碱(氢氧化钠),Pb(OH)2 表示碱式碘化铅,NaI 表示碘化钠。

原文地址: http://www.cveoy.top/t/topic/iC1o 著作权归作者所有。请勿转载和采集!
安全问答是一个知识全球问答,包含丰富的问答知识
碘化铅可以和碱反应生成碘化物。下面是一个可能的反应方程式: PbI2 + 2NaOH → Pb(OH)2 + 2NaI 其中,PbI2 表示碘化铅,NaOH 表示碱(氢氧化钠),Pb(OH)2 表示碱式碘化铅,NaI 表示碘化钠。
原文地址: http://www.cveoy.top/t/topic/iC1o 著作权归作者所有。请勿转载和采集!